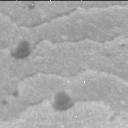

Curiosity Raw Images
Sol 3610: Mast Camera (Mastcam)

This image was taken by Mast Camera (Mastcam) onboard NASA's Mars rover Curiosity on Sol 3610 (2022-10-02 08:01:49 UTC).
Credits: NASA/JPL-Caltech/MSSS
This image was taken by Mast Camera (Mastcam) onboard NASA's Mars rover Curiosity on Sol 3610 (2022-10-02 08:01:49 UTC).
Credits: NASA/JPL-Caltech/MSSS